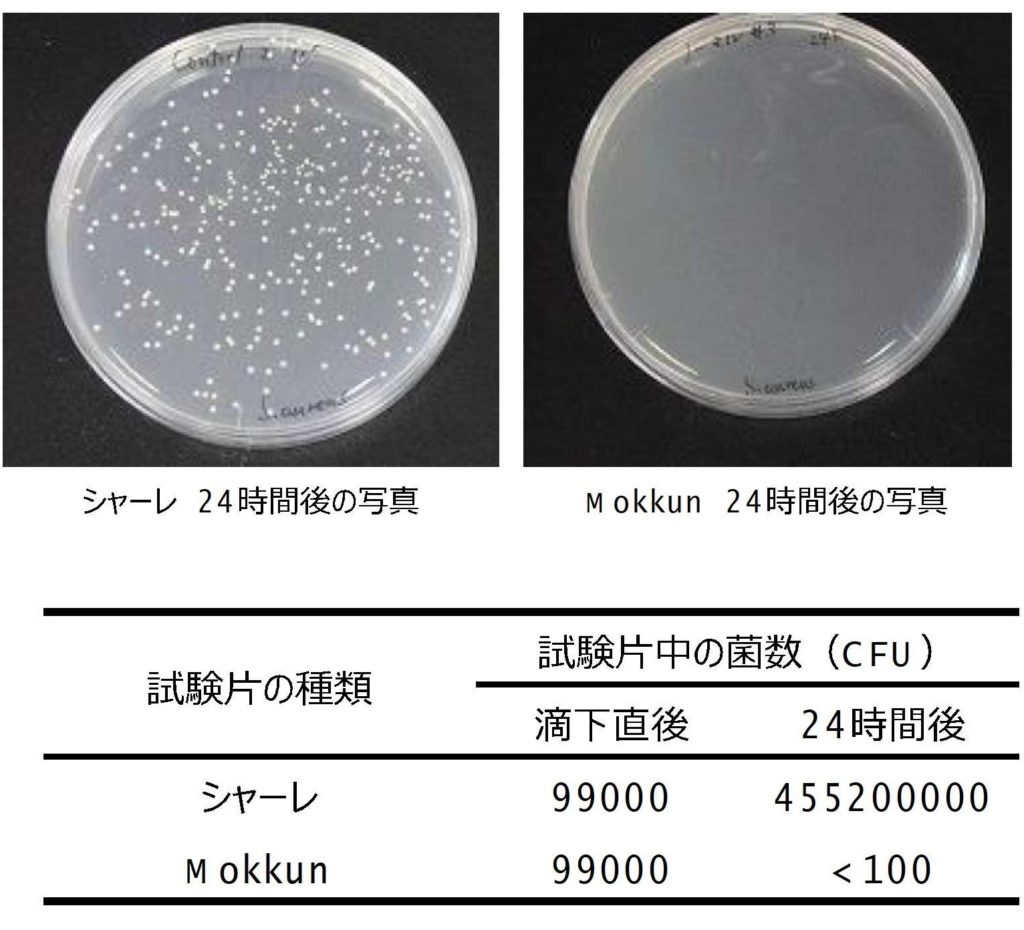

Q: 木材には抗菌作用がありますか?
A: 精油などには低分子化合物が含まれており、それにより抗菌効果がもたらされます。
データ1
スギの精油や抽出物には、黄色ブドウ球菌に対し強い抗菌活性が報告されています(下表)。
精油では、主にテルペン類などの低沸点化合物によって、菌の生育抑制または殺菌効果が発揮されたと考えられます。また、残渣のメタノール抽出物では、精油には抽出されにくい一部のジテルペン類やポリフェノールなどの比較的高沸点の化合物によって、同様の効果が発揮されたと考えられます。またこれとは別に、ニオイヒバ、ヒノキ、チャボヒバ、ヒノキアスナロ、ツガ、ストローブマツの精油は、カビの生育を阻害したことが報告されています。
スギ精油および精油抽出残渣の抗菌効果
出典(上表):Nakagawa, T., et al.: J. Wood Chem. Technol., 36, 42-55 (2016) [ 一部改変]
データ2
木の塗り壁Mokkunにおいては、黄色ブドウ球菌に対する抗菌性が実証されています。
試験:岐阜薬科大学 感染制御学研究室